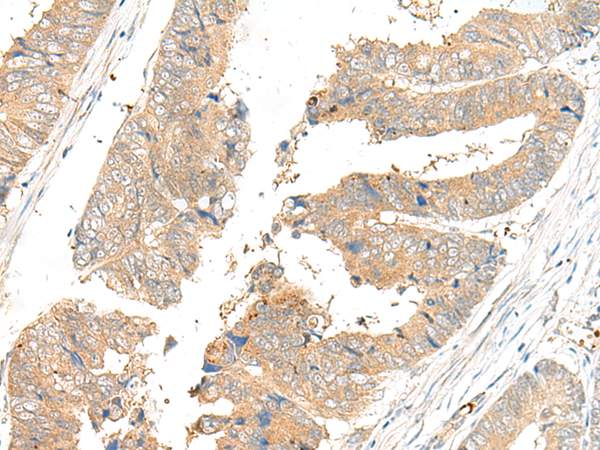
一抗

|
Background: |
The protein encoded by this gene is a mitochondrial phosphate-activated glutaminase that catalyzes the hydrolysis of glutamine to stoichiometric amounts of glutamate and ammonia. Originally thought to be liver-specific, this protein has been found in other tissues as well. Alternative splicing results in multiple transcript variants that encode different isoforms. |
|
Applications: |
ELISA, WB, IHC |
|
Name of antibody: |
GLS2 |
|
Immunogen: |
Synthetic peptide of human GLS2 |
|
Full name: |
glutaminase 2 |
|
Synonyms: |
GA; GLS; LGA; hLGA |
|
SwissProt: |
Q9UI32 |
|
ELISA Recommended dilution: |
5000-10000 |
|
IHC positive control: |
Human colorectal cancer |
|
IHC Recommend dilution: |
40-200 |
|
WB Predicted band size: |
66 kDa |
|
WB Positive control: |
Mouse liver tissue lysate |
|
WB Recommended dilution: |
500-2000 |


 購(gòu)物車
購(gòu)物車 幫助
幫助
 021-54845833/15800441009
021-54845833/15800441009